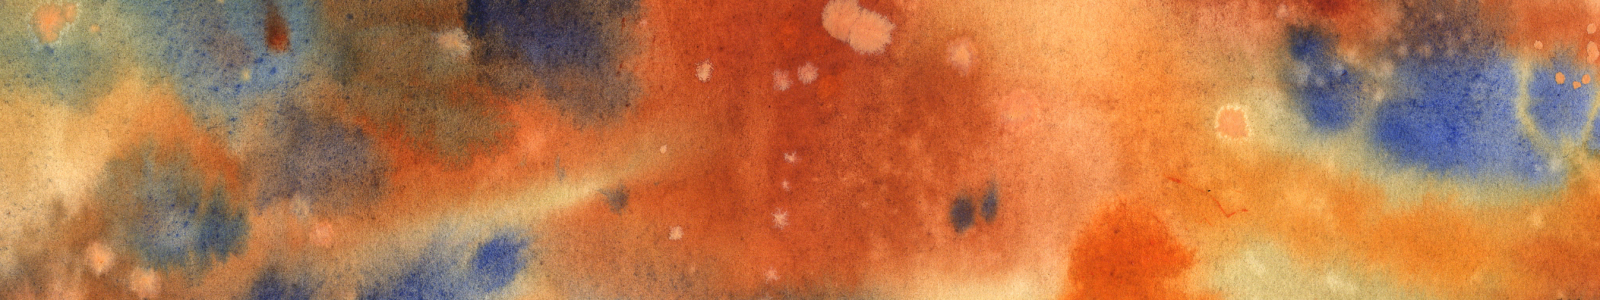

Künstler
Veronika Shepilova
Krasnogorsk, Russland
Pomegranate
Veronika Shepilova (geb. 1996)
Shepilova Veronika

Veronika Shepilova
17.10.1996
Russland
All my life I wanted to create art! I have art education as animation and computer graphics artist.
I love to draw everything: nature, people, emotions and impressions. Watercolor is my favorite technique. Now I am 24 y.o. and I want to share my collection of art with the world . All of my art contains a piece of my soul.
Memories of the sea
Veronika Shepilova (geb. 1996)
Shepilova Veronika

Veronika Shepilova
17.10.1996
Russland
All my life I wanted to create art! I have art education as animation and computer graphics artist.
I love to draw everything: nature, people, emotions and impressions. Watercolor is my favorite technique. Now I am 24 y.o. and I want to share my collection of art with the world . All of my art contains a piece of my soul.